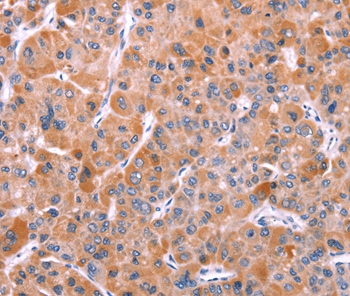
产品细节图片2

相关产品推荐更多 >
万千商家帮你免费找货
0 人在求购买到急需产品
- 详细信息
- 文献和实验
- 技术资料
- 免疫原:
Synthetic peptide corresponding to a region derived from internal residues of human breakpoint cluster region
- 形态:
liquid
- 保存条件:
Store at -20˚C
- 克隆性:
Polyclonal
- 适应物种:
Human;Mouse
- 保质期:
12 months
- 抗原来源:
Rabbit
- 供应商:
南京赛戈巍生物科技有限公司
- 宿主:
Rabbit
- 应用范围:
IHC
- 靶点:
Uniprot:P11274
- 抗体英文名:
BCR Antibody
- 规格:
50ul/100ul
配方:Rabbit IgG in pH7.3 PBS, 0.05% NaN3, 50% Glycerol.
应用详情:Immunohistochemistry: 1:25-1:100
图片:

Immunohistochemical analysis of paraffin-embedded Human thyroid cancer tissue using #37152 at dilution 1/15.
,
Immunohistochemical analysis of paraffin-embedded Human liver cancer tissue using #37152 at dilution 1/15.
风险提示:丁香通仅作为第三方平台,为商家信息发布提供平台空间。用户咨询产品时请注意保护个人信息及财产安全,合理判断,谨慎选购商品,商家和用户对交易行为负责。对于医疗器械类产品,请先查证核实企业经营资质和医疗器械产品注册证情况。
文献和实验免疫组库是哪位? 能够称为“组库”,首先是功能相似的N多细胞的集合。而“免疫”是指免疫细胞,特指 T/B 淋巴细胞。“So~免疫组库”(Immune Repertoire,IR),指某个体,特定时间点下,所有功能多样性T/B淋巴细胞的总和。T/B细胞利用细胞表面受体(TCR/BCR)识别和结合抗原,介导机体产生针对性的免疫应答,发挥免疫功能并做好记录备案,如果该抗原再次入侵可迅速作出反应,作为健康卫士守护肌体城池。 “组库”从哪来? 除了 n 多 T/B 细胞的集合,TCR/BCR
免疫组库是哪位? 能够称为“组库”,首先是功能相似的N多细胞的集合。而“免疫”是指免疫细胞,特指T/B淋巴细胞。“So~免疫组库”(Immune Repertoire,IR),指某个体,特定时间点下,所有功能多样性T/B淋巴细胞的总和。T/B细胞利用细胞表面受体(TCR/BCR)识别和结合抗原,介导机体产生针对性的免疫应答,发挥免疫功能并做好记录备案,如果该抗原再次入侵可迅速作出反应,作为健康卫士守护肌体城池。 “组库”从哪来? 除了n多T/B细胞的集合,TCR/BCR多样
Fluorescence In Situ Hybridization for BCR-ABL
The BCR-ABL fusion gene arises as a result of a reciprocal translocation between chromosomes 9 and 22, resulting in the so-called Philadelphia (Ph) chromosome (a minute chromosome 22), which is found in 95% of cases of chronic myeloid
技术资料暂无技术资料 索取技术资料





![DCAF5 Antibody[47027]](https://img1.dxycdn.com/p/s14/2025/0923/496/0462304380155040791.jpg!wh200)
![Integrin linked ILK Conjugated Antibody[C48993]](https://img1.dxycdn.com/p/s14/2025/0923/305/2150219664296040791.jpg!wh200)
![NUP50 Conjugated Antibody[C36664]](https://img1.dxycdn.com/p/s14/2025/0923/278/4431488150116040791.jpg!wh200)
![DDR2 Antibody[37159]](https://img1.dxycdn.com/p/s14/2025/0922/359/6146153295428599691.jpg!wh200)

